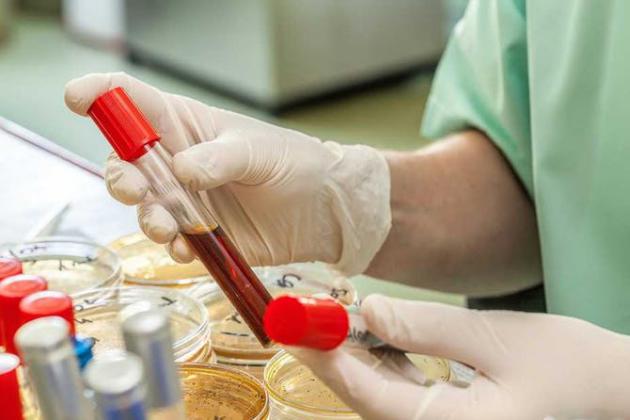

أم "تمص" دم طفلها منذ 5 أعوام
دانت محكمة دنماركية، مؤخرا، امرأة بالحبس أربع سنوات، بعدما ظلت تعتدي على ابنها بشكل "دموي" طيلة خمسة أعوام، وبحسب موقع "إن دي تي في"، فإن الأم التي تعمل ممرضة، كانت تسحب نصف لتر من دم الابن بشكل أسبوعي دون أي رأفة، في مقاطعة هرنينغ، وسط البلاد، وبدأت المرأة البالغة من العمر 36 عاما، بسحب دم الابن منذ شهره الحادي عشر، وقالت أمام المحكمة بأنها أقدمت على فعلتها الشنيعة دون وعي.
ونقل موقع سكاي نيوز، الخبر والذي جاء فيه من أقوال الأم المتوحشة أنها كانت تسكب دم الطفل داخل الحمام ثم تقوم بإلقاء الإبر في القمامة، وأضافت الأم أنها لا تعرف متى بدأت في إيذاء الابن الضحية، ويعيش الطفل الذي يبلغ في يومنا هذا 7 أعوام من العمر إلى جانب أبيه، وتقول العائلة إنه عانى مشكلة في الأمعاء بعد ميلاده مباشرة.
ومع تقدمه في العمر، أبدى الأطباء حيرة إزاء الطفل، ولم يعرفوا سبب قلة الدم داخل جسمه، ولحل هذه الأزمة، دأب الأطباء على حقنه بالدم 110 مرات على مدى سنوات، وحين سرت الشكوك، أجرت الشرطة تحقيقا في الأمر، وتم التوصل إلى الجانية التي لم تكن سوى الأم، وتم اعتقال "مصاصة الدماء" في سبتمبر 2017 وهي تحمل كيسا من الدم.
وبحسب خبراء نفسانيين استعانت بهم المحكمة، تعاني الأم من متلازمة نادرة تنتشر بين بعض الأمهات اللائي يحاولن اختلاق مرض أحد الأقارب بغرض دفعهم إلى الخضوع للعلاج، ويقول الخبراء إن الأم تتمتع بصحة جيدة ولن تنفد من عقوبة الحبس التي أصدرتها المحكمة.



